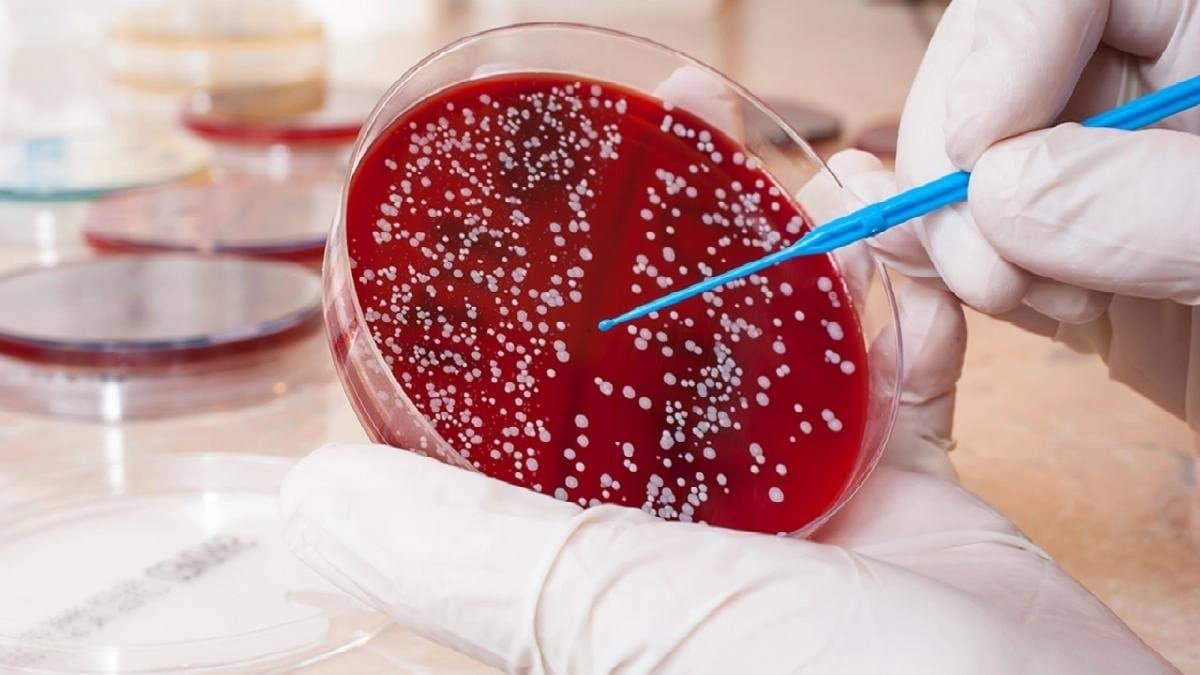
Blood Cancer Awareness month the major symptoms of blood Cancer

আজকাল ওয়েবডেস্ক: সেপ্টেম্বর মাস গোটা বিশ্বে ‘ব্লাড ক্যানসার সচেতনতা মাস’ হিসাবে পালিত হয়। লিউকেমিয়া, লিম্ফোমা বা মায়ালোমা- এই তিন ধরনের ক্যানসারই মূলত ‘ব্লাড ক্যানসার’ নামে পরিচিত। শরীরের অস্থিমজ্জায় রক্তের কোষগুলির অস্বাভাবিক এবং অনিয়ন্ত্রিত বৃদ্ধি থেকেই এই মারাত্মক রোগের সূত্রপাত।
বিশেষজ্ঞদের মতে, এই রোগের এমন কিছু প্রাথমিক উপসর্গ রয়েছে, যা আমরা প্রায়শই সাধারণ ক্লান্তি বা ভাইরাল জ্বর ভেবে অবলীলায় এড়িয়ে যাই। আর সেই অবহেলার মাসুল হতে পারে মারাত্মক।
সচেতনতার লক্ষ্যই হল, বিপদের সেই লক্ষণগুলিকে প্রাথমিক স্তরেই চিনে নেওয়া। কারণ, যে কোনও ক্যানসারের ক্ষেত্রেই যত দ্রুত রোগ নির্ণয় করা যায়, ততই চিকিৎসার সাফল্যের হার বাড়ে।
কোন কোন উপসর্গ দেখলে সতর্ক হবেন?
চিকিৎসকেরা জানাচ্ছেন, ব্লাড ক্যানসারের উপসর্গগুলি অনেক সময়েই অন্য সাধারণ রোগের উপসর্গের সঙ্গে মিলে যেতে পারে। তবে দীর্ঘ দিন ধরে এগুলি চলতে থাকলে অবশ্যই চিকিৎসকের পরামর্শ নেওয়া উচিত।
১। অস্বাভাবিক ক্লান্তি এবং দুর্বলতা: কোনও কারণ ছাড়াই যদি শরীর অতিরিক্ত ক্লান্ত বা দুর্বল লাগে এবং পর্যাপ্ত বিশ্রামের পরেও সেই ক্লান্তি না কাটে, তবে তা চিন্তার কারণ হতে পারে। রক্তের লোহিত রক্তকণিকা কমে গেলে এই সমস্যা দেখা দেয়।
২। বারবার সংক্রমণ ও জ্বর: ব্লাড ক্যানসার শরীরের রোগ প্রতিরোধ ক্ষমতাকে দুর্বল করে দেয়। এর ফলে ঘন ঘন জ্বর এবং নানা ধরনের সংক্রমণ (যেমন- গলা বা ত্বকের সংক্রমণ) হতে থাকে, যা সহজে সারতে চায় না।
আরও পড়ুন: স্ত্রীর পিঠ জিভ দিয়ে চেটে দেয় পুরুষ, স্ত্রী যদি পাল্টা লেহন করে, তবেই হয় মিলন! পৃথিবীর একমাত্র জীবিত ড্রাগন এরাই
৩। ত্বকে অস্বাভাবিক দাগ: শরীরে লোহিত রক্তকণিকা বা প্লেটলেট কমে গেলে সামান্য আঘাতেই ত্বকে কালশিটে দাগ পড়ে যেতে পারে। এছাড়া ত্বকের নিচে ছোট ছোট লাল বিন্দুর মতো র্যাশ দেখা দেওয়াও অন্যতম লক্ষণ।
৪। অকারণে রক্তপাত: প্লেটলেট কমে যাওয়ার কারণে অনেক সময়ে মাড়ি বা নাক থেকে হঠাৎ রক্তপাত হতে পারে। ঋতুস্রাবের সময় অতিরিক্ত রক্তপাতও একটি উপসর্গ হতে পারে।
৫। শরীরের বিভিন্ন অংশ ফুলে যাওয়া: ঘাড়, বগল বা কুঁচকির লসিকা গ্রন্থি কোনও কারণ ছাড়াই ফুলে ওঠা লিম্ফোমার অন্যতম প্রধান লক্ষণ। এছাড়া প্লীহা বড় হয়ে যাওয়ার কারণে পেটের বাঁ দিকে উপরের অংশে ফোলা ভাব বা ব্যথা অনুভূত হতে পারে।
৬। হাড় ও গাঁটে ব্যথা: অস্থিমজ্জায় অস্বাভাবিক কোষের সংখ্যা বেড়ে গেলে হাড়ে বা গাঁটে তীব্র ব্যথা হতে পারে। বিশেষত মায়ালোমার ক্ষেত্রে এই উপসর্গটি বেশি দেখা যায়।
আরও পড়ুন: স্ত্রীর পিঠ জিভ দিয়ে চেটে দেয় পুরুষ, স্ত্রী যদি পাল্টা লেহন করে, তবেই হয় মিলন! পৃথিবীর একমাত্র জীবিত ড্রাগন এরাই
৭। হঠাৎ ওজন কমে যাওয়া: কোনও নির্দিষ্ট কারণ বা চেষ্টা ছাড়াই যদি দ্রুত ওজন কমতে থাকে, খিদে চলে যায় এবং রাতে ঘাম হয়, তবে তা অবহেলা করা উচিত নয়।
চিকিৎসকদের মতে, এই উপসর্গগুলির কোনও একটি বা একাধিক যদি দীর্ঘ দিন ধরে দেখা যায়, তবে আতঙ্কিত না হয়ে অবিলম্বে বিশেষজ্ঞ চিকিৎসকের (হেমাটোলজিস্ট) পরামর্শ নেওয়া উচিত। সাধারণ রক্ত পরীক্ষাই অনেক সময়ে প্রাথমিক ইঙ্গিত দিতে পারে। মনে রাখতে হবে, ক্যানসারের বিরুদ্ধে লড়াইয়ে সবচেয়ে বড় হাতিয়ার হল সচেতনতা এবং দ্রুত রোগ নির্ণয়। তাই নিজে সচেতন হন এবং অন্যকেও সচেতন করুন। সামান্য সতর্কতা বহু ক্ষেত্রে জীবনদায়ী হয়ে উঠতে পারে।